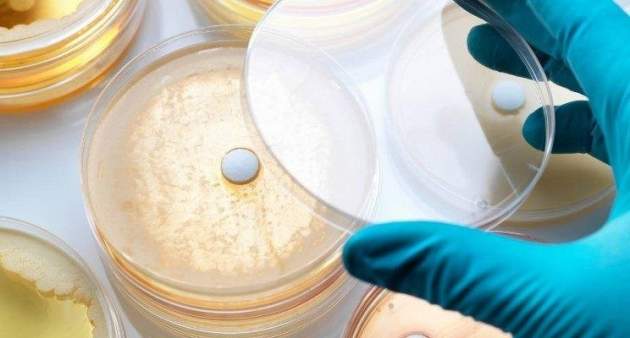

Пока медики борются с гриппом и думают, как остановить корь, человечество пугает еще одна серьезная проблема – супербактерии. Их не берет ни один известный антибиотик. Ежегодно они уносят жизни более семисот тысяч человек.
По прогнозам исследователей, за 30 лет цифры достигнут десяти миллионов. Некоторые бактерии убийцы медики уже нашли в Украине, передает segodnya.ua.
Нашли супербактерии в водах Дуная. Врачи уверены, эти микроорганизмы уже среди нас. И в каком регионе Украины угроза самая высокая, пока не берется сказать никто. Потому что никто за этим не следит.
Инфекционистка Алла Волоха оценивает ситуацию как возвращение во времена естественного отбора, когда выживает тот, кто крепче.
Одна из причин появления супербактерий – неправильное употребление антибиотиков. Мы пьем их при любом проявлении простуды, но этим только учим бактерии быть сильнее.
«Сейчас идет сразу назначение антибиотиков последнего поколения, когда у врачей и пациентов, практически, не остается выбора, если антибиотик не подействует», – говорит Владимир Руденко, доктор фармацевтических наук.
Создание новых видов антибиотиков – процесс длительный. Принципиально новый препарат теиксобактин ожидают не ранее 2025 года. Но никто не гарантирует, что и к нему бактерии впоследствии не приобретут устойчивости.
- intense_post_subtitle:
- intense_post_single_template:
- intense_featured_gallery:
- intense_featured_image_type:
- standard
- intense_image_shadow:
- null
- intense_hover_effect_type:
- null
- intense_hover_effect:
- 0
- intense_featured_audio_url:
- intense_featured_video_type:
- intense_featured_color:

